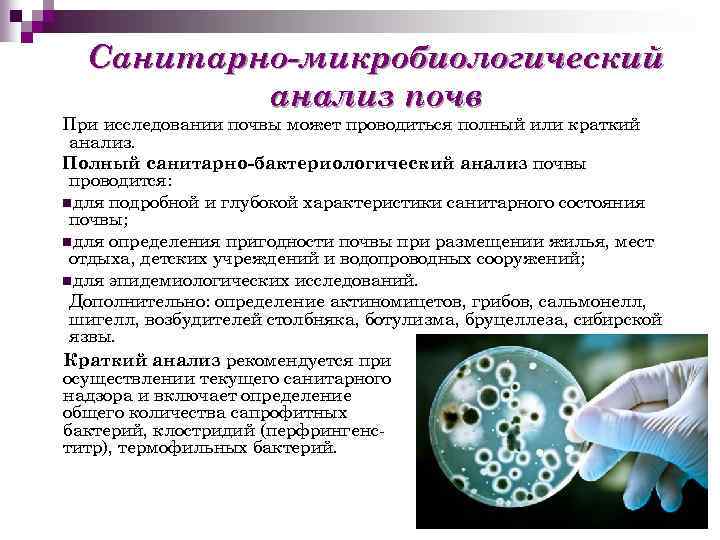
Санитарно-микробиологический анализ почв При исследовании почвы может проводиться полный или краткий анализ. Полный санитарно-бактериологический

Лекция 12 ЭМ.ppt
- Количество слайдов: 31
 Микроорганизмы водоёмов, воздуха и почв Лекция № 12 по дисциплине «Экология микроорганизмов»
Микроорганизмы водоёмов, воздуха и почв Лекция № 12 по дисциплине «Экология микроорганизмов»
 План лекции: n n n n n Уникальные свойства воды. Гидромикрофлора и ее особенности. Олиготрофные и эвтрофные водоемы и факторы это определяющие. Лимнология. Санитарно-показательные микроорганизмы. Микроорганизмы воздуха. Микробиологический контроль качества воздушной среды. Микробиоценозы почв. Структура почвенных микробных сообществ. Роль микроорганизмов в формировании плодородия почв.
План лекции: n n n n n Уникальные свойства воды. Гидромикрофлора и ее особенности. Олиготрофные и эвтрофные водоемы и факторы это определяющие. Лимнология. Санитарно-показательные микроорганизмы. Микроорганизмы воздуха. Микробиологический контроль качества воздушной среды. Микробиоценозы почв. Структура почвенных микробных сообществ. Роль микроорганизмов в формировании плодородия почв.
 Микробиоценозы водоёмов
Микробиоценозы водоёмов
 Уникальные свойства воды n Вода – идеальная среда обитания микроорганизмов. Бактерии не способны к жизнедеятельности вне жидкой воды. n Необычные свойства воды объясняются строением её молекулы. n В жидкой фазе образуются агрегаты, в твёрдой – кристаллическая структура. Аномальная зависимость плотности от температуры, Теплопроводность, Полярность воды. n n n
Уникальные свойства воды n Вода – идеальная среда обитания микроорганизмов. Бактерии не способны к жизнедеятельности вне жидкой воды. n Необычные свойства воды объясняются строением её молекулы. n В жидкой фазе образуются агрегаты, в твёрдой – кристаллическая структура. Аномальная зависимость плотности от температуры, Теплопроводность, Полярность воды. n n n
 История исследования водных микроорганизмов n Микроскопическое исследование водных микроорганизмов началось в середине XIX в. (Ф. Кон). Первыми в поле зрения микроскопистов попали крупные нитчатые бактерии, как Beggiatoa, Thioploca, Crenothrix, Sphaerotilus, Gallionella, Leptothrix, Peloploca. n Период количественного учета бактерий в воде. Воду испаряли в цилиндре на поверхности предметного стекла. n Следующим этапом в развитии прямых методов было использование мембранных фильтров из нитроцеллюлозы (А. С. Разумов, А. Е. Крисе). n Прямому методу противостояли методы культивирования Р. Коха с подсчетом числа колоний на агаризованных средах и идентификацией индикаторных организмов во главе с Escherichia coli для установления «коли-титра» , разработанные санитарными бактериологами в 1880 -е годы. n Разработка молекулярных методов идентификации и филогенетического положения «некультивируемых» организмов. Ф. Кон Р. Кох
История исследования водных микроорганизмов n Микроскопическое исследование водных микроорганизмов началось в середине XIX в. (Ф. Кон). Первыми в поле зрения микроскопистов попали крупные нитчатые бактерии, как Beggiatoa, Thioploca, Crenothrix, Sphaerotilus, Gallionella, Leptothrix, Peloploca. n Период количественного учета бактерий в воде. Воду испаряли в цилиндре на поверхности предметного стекла. n Следующим этапом в развитии прямых методов было использование мембранных фильтров из нитроцеллюлозы (А. С. Разумов, А. Е. Крисе). n Прямому методу противостояли методы культивирования Р. Коха с подсчетом числа колоний на агаризованных средах и идентификацией индикаторных организмов во главе с Escherichia coli для установления «коли-титра» , разработанные санитарными бактериологами в 1880 -е годы. n Разработка молекулярных методов идентификации и филогенетического положения «некультивируемых» организмов. Ф. Кон Р. Кох
 Гидрологический цикл Микроорганизмы воды играют значительную роль в круговороте веществ, расщепляя органические вещества животного и растительного происхождения и обеспечивая питательными веществами другие организмы, живущие в воде.
Гидрологический цикл Микроорганизмы воды играют значительную роль в круговороте веществ, расщепляя органические вещества животного и растительного происхождения и обеспечивая питательными веществами другие организмы, живущие в воде.
 Гидромикрофлора и ее особенности n n n Глубокие почвенные воды, ключевая, артезианская вода почти свободны от микроорганизмов. Незначительно бывают загрязненными атмосферные осадки. Количественные соотношения микроорганизмов в открытых водоемах варьируют в широких пределах, что зависит от типа водоема, степени его загрязнения, смены метеорологических условий сезона и т. д. В реках вода загрязняется в большей степени отбросами населенных пунктов. В озерной воде отмечается четкое вертикальное распределение бактерий. В открытые водоемы большинство микробов попадает из почвы → больше всего микробов у берегов.
Гидромикрофлора и ее особенности n n n Глубокие почвенные воды, ключевая, артезианская вода почти свободны от микроорганизмов. Незначительно бывают загрязненными атмосферные осадки. Количественные соотношения микроорганизмов в открытых водоемах варьируют в широких пределах, что зависит от типа водоема, степени его загрязнения, смены метеорологических условий сезона и т. д. В реках вода загрязняется в большей степени отбросами населенных пунктов. В озерной воде отмечается четкое вертикальное распределение бактерий. В открытые водоемы большинство микробов попадает из почвы → больше всего микробов у берегов.
 Характеристики водоёмов n n Олиготрофные, Евтрофные, Мезотрофные, Гипертрофные водоемы n Эпилимнион На поверхности водоема микроорганизмы образуют пленку, в которой происходит фотосинтез, концентрируются эндогенные питательные вещества. Совокупность микроорганизмов – нейстон. n Металимнион Содержание биогенных минеральных веществ выше, чем в эпилимнионе. Развитие аэробов лимитировано недостатком кислорода. n Гиполимнион На дне, особенно илистом, благоприятны анаэробные условия для гниения и брожения, хемоаутотрофного, метилтрофного и гетеротрофного синтеза. Стратификация и перемешивание воды в озере (по Э. Понтеру и др. , 1982)
Характеристики водоёмов n n Олиготрофные, Евтрофные, Мезотрофные, Гипертрофные водоемы n Эпилимнион На поверхности водоема микроорганизмы образуют пленку, в которой происходит фотосинтез, концентрируются эндогенные питательные вещества. Совокупность микроорганизмов – нейстон. n Металимнион Содержание биогенных минеральных веществ выше, чем в эпилимнионе. Развитие аэробов лимитировано недостатком кислорода. n Гиполимнион На дне, особенно илистом, благоприятны анаэробные условия для гниения и брожения, хемоаутотрофного, метилтрофного и гетеротрофного синтеза. Стратификация и перемешивание воды в озере (по Э. Понтеру и др. , 1982)
 Характеристики водных микроорганизмов n n n n Основные категории микроорганизмов Планктон - основные организмы водной толщи Гаптобентос – микроорганизмы, прикрепляющиеся к плавающим частичкам и водным растениям Перифитон, включающий бентосные микроорганизмы, обитающие непосредственно в донных осадках Продуценты Деструкторы Автохтонная или собственная микрофлора представлена микроорганизмами (см. рис. ), постоянно живущими и размножающимися в воде. В состав этой группы входят Micrococcus candicans, Sarcina lutea, Pseudomonas fluorescens, Bacillus cereus и др. Аллохтонная или заносная микрофлора попадает в открытые водоемы из почвы, воздуха, организмов животных и человека и резко изменяет микробный биоценоз и санитарный режим. Sarcina lutea Pseudomonas fluorescens Bacillus cereus
Характеристики водных микроорганизмов n n n n Основные категории микроорганизмов Планктон - основные организмы водной толщи Гаптобентос – микроорганизмы, прикрепляющиеся к плавающим частичкам и водным растениям Перифитон, включающий бентосные микроорганизмы, обитающие непосредственно в донных осадках Продуценты Деструкторы Автохтонная или собственная микрофлора представлена микроорганизмами (см. рис. ), постоянно живущими и размножающимися в воде. В состав этой группы входят Micrococcus candicans, Sarcina lutea, Pseudomonas fluorescens, Bacillus cereus и др. Аллохтонная или заносная микрофлора попадает в открытые водоемы из почвы, воздуха, организмов животных и человека и резко изменяет микробный биоценоз и санитарный режим. Sarcina lutea Pseudomonas fluorescens Bacillus cereus
 Загрязнение воды Время выживания аллохтонной микрофлоры водоемов определяется: — интенсивностью процессов самоочищения воды; — таксономической принадлежностью самого микроорганизма (его биологическими свойствами: способностью к спорообразованию); — устойчивостью к высушиванию или к солнечной радиации. Возбудитель сибирской язвы Возбудители холеры Энтеровирус Сальмонелла дизентерии Лептоспира бруцеллёза
Загрязнение воды Время выживания аллохтонной микрофлоры водоемов определяется: — интенсивностью процессов самоочищения воды; — таксономической принадлежностью самого микроорганизма (его биологическими свойствами: способностью к спорообразованию); — устойчивостью к высушиванию или к солнечной радиации. Возбудитель сибирской язвы Возбудители холеры Энтеровирус Сальмонелла дизентерии Лептоспира бруцеллёза
 Санитарно-микробиологический анализ воды n n Общее микробное число – количественный показатель бактериальной зараженности окружающей среды, представляющий собой число выросших на мясопептонном arape колоний, приходящихся на 1 мл жидкости. Бактерии группы кишечной палочки (БГКП, колиморфными и колиформными бактериями) – группа бактерий семейства энтеробактерий, используемая санитарной микробиологией в качестве маркера фекальной контаминации. Коли-индекс – количественный показатель бактериологического загрязнения, определяемый количеством БГКП – Escherichia coli в 1 л исследуемого объекта; величина, пропорциональная фактическому содержанию кишечной палочки в исследуемом субстрате. Коли-титр – это наименьшее количество исследуемого материала в миллилитрах, в котором обнаружена одна кишечная палочка.
Санитарно-микробиологический анализ воды n n Общее микробное число – количественный показатель бактериальной зараженности окружающей среды, представляющий собой число выросших на мясопептонном arape колоний, приходящихся на 1 мл жидкости. Бактерии группы кишечной палочки (БГКП, колиморфными и колиформными бактериями) – группа бактерий семейства энтеробактерий, используемая санитарной микробиологией в качестве маркера фекальной контаминации. Коли-индекс – количественный показатель бактериологического загрязнения, определяемый количеством БГКП – Escherichia coli в 1 л исследуемого объекта; величина, пропорциональная фактическому содержанию кишечной палочки в исследуемом субстрате. Коли-титр – это наименьшее количество исследуемого материала в миллилитрах, в котором обнаружена одна кишечная палочка.
 Санитарно-микробиологический анализ воды Санитарно-показательные n n n микроорганизмы, постоянно обитающие в естественных полостях тела человека и животных - это санитарнопоказательные микроорганизмы кишечника (группа А) и верхних отделов дыхательных путей (группа Б). К группе А относятся кишечная палочка, энтерококк, Clostridium реrfringens, Proteus mirabilis, Pseudomonas aeruginosa, Lactobacterium bifidum, Lactobacterium plantarum, кишечный и дизентерийный бактериофаги, Bacteroides (Risiella). Группа Б включает зеленящий стрептококк, гемолитический стрептококк, стафилокок. E. coli Clostridium регfringens Proteus mirabilis
Санитарно-микробиологический анализ воды Санитарно-показательные n n n микроорганизмы, постоянно обитающие в естественных полостях тела человека и животных - это санитарнопоказательные микроорганизмы кишечника (группа А) и верхних отделов дыхательных путей (группа Б). К группе А относятся кишечная палочка, энтерококк, Clostridium реrfringens, Proteus mirabilis, Pseudomonas aeruginosa, Lactobacterium bifidum, Lactobacterium plantarum, кишечный и дизентерийный бактериофаги, Bacteroides (Risiella). Группа Б включает зеленящий стрептококк, гемолитический стрептококк, стафилокок. E. coli Clostridium регfringens Proteus mirabilis
 Микроорганизмы воздушной среды
Микроорганизмы воздушной среды
 История исследования микроорганизмов воздуха Начало микробиологическому анализу воздуха было положено Луи Пастером, экспериментально доказавшим наличие микроорганизмов в воздухе. Микробиологические исследования воздуха в жилых домах, школах и других общественных помещениях ведутся уже более ста лет. Целью первых исследований являлось определение «чистоты» различных типов помещений и выявление возможной связи с уровнем смертности их обитателей. 40 -50 -е гг. – систематические исследования по изучению микробиологического состава воздуха больниц; открытие аллергенных разновидностей плесени воздуха жилищ, общественных зданий и улицы. 50 -60 -е гг. – изучение профессиональных заболеваний органов дыхания среди фермеров и рабочих, контактирующих с солодом и хлопком.
История исследования микроорганизмов воздуха Начало микробиологическому анализу воздуха было положено Луи Пастером, экспериментально доказавшим наличие микроорганизмов в воздухе. Микробиологические исследования воздуха в жилых домах, школах и других общественных помещениях ведутся уже более ста лет. Целью первых исследований являлось определение «чистоты» различных типов помещений и выявление возможной связи с уровнем смертности их обитателей. 40 -50 -е гг. – систематические исследования по изучению микробиологического состава воздуха больниц; открытие аллергенных разновидностей плесени воздуха жилищ, общественных зданий и улицы. 50 -60 -е гг. – изучение профессиональных заболеваний органов дыхания среди фермеров и рабочих, контактирующих с солодом и хлопком.
 Микроорганизмы воздуха Ø Количество микроорганизмов в 1 м 4 воздуха разных мест может достигать следующих размеров: Ø в скотном дворе до 2 млн; Ø в жилых помещениях – 20 тыс; Ø на улицах городов - 5 тыс; Ø в парках - 200; Ø в морском воздухе - 1 -2. Ø Ø Состав микрофлоры: микрококки Ø сарцины Ø споры грибов Ø дрожжи Ø актиномицеты Ø спороносные бациллы Ø клостридии Ø возбудители гриппа, коклюша, ангины, кори, скарлатины. Ø
Микроорганизмы воздуха Ø Количество микроорганизмов в 1 м 4 воздуха разных мест может достигать следующих размеров: Ø в скотном дворе до 2 млн; Ø в жилых помещениях – 20 тыс; Ø на улицах городов - 5 тыс; Ø в парках - 200; Ø в морском воздухе - 1 -2. Ø Ø Состав микрофлоры: микрококки Ø сарцины Ø споры грибов Ø дрожжи Ø актиномицеты Ø спороносные бациллы Ø клостридии Ø возбудители гриппа, коклюша, ангины, кори, скарлатины. Ø
 Три группы микроорганизмов воздуха ØПигментообразующие кокки – в солнечные дни составляют до 70 -80% всей флоры. ØПочвенные споровые и гнилостные микроорганизмы. Их содержание резко увеличивается в сухую и ветреную погоду. ØПлесневые грибы и дрожжи. Содержание увеличивается при повышении влажности воздуха.
Три группы микроорганизмов воздуха ØПигментообразующие кокки – в солнечные дни составляют до 70 -80% всей флоры. ØПочвенные споровые и гнилостные микроорганизмы. Их содержание резко увеличивается в сухую и ветреную погоду. ØПлесневые грибы и дрожжи. Содержание увеличивается при повышении влажности воздуха.
 Микроорганизмы атмосферного воздуха Ø Ø Состав зависит от микрофлоры почвы, воды, от времени года, климатических и метеорологических условий, малочислен и вариабелен. Наибольшее количество микробов содержит воздух промышленных городов. Воздух сельских мест гораздо чище. Основная масса микроорганизмов находится у поверхности земли, в тропосфере.
Микроорганизмы атмосферного воздуха Ø Ø Состав зависит от микрофлоры почвы, воды, от времени года, климатических и метеорологических условий, малочислен и вариабелен. Наибольшее количество микробов содержит воздух промышленных городов. Воздух сельских мест гораздо чище. Основная масса микроорганизмов находится у поверхности земли, в тропосфере.
 Микроорганизмы воздуха помещений Ø Ø Ø Состав воздуха помещений зависит от их объема, частоты проветривания, качества уборки, степени освещенности и посещаемости. Воздух может содержать микрофлору верхних дыхательных путей и кожи человека. Количество микроорганизмов почти не зависит от сезонов года. Необходимо проводить уборку с использованием дезинфицирующих средств. В помещениях с большим количеством растений воздух более чист за счет вырабатываемых растениями фитонцидов.
Микроорганизмы воздуха помещений Ø Ø Ø Состав воздуха помещений зависит от их объема, частоты проветривания, качества уборки, степени освещенности и посещаемости. Воздух может содержать микрофлору верхних дыхательных путей и кожи человека. Количество микроорганизмов почти не зависит от сезонов года. Необходимо проводить уборку с использованием дезинфицирующих средств. В помещениях с большим количеством растений воздух более чист за счет вырабатываемых растениями фитонцидов.
 Микроорганизмы воздуха помещений Некоторые типы грибов, способных вызывать ринит и/или астму, в воздухе помещений Alternaria Eurotium Wallemia Fusarium Aspergillus Mucor Cladosporium Penicillium
Микроорганизмы воздуха помещений Некоторые типы грибов, способных вызывать ринит и/или астму, в воздухе помещений Alternaria Eurotium Wallemia Fusarium Aspergillus Mucor Cladosporium Penicillium
 Микробный аэрозоль – это взвесь в воздухе живых или убитых микробных клеток, адсорбированных на пылевых частицах или заключенных в «капельные ядра» . Включает частицы размером от 0, 001 до 100 мкм. Размер частиц определяет 2 важных параметра аэрозоля: 1) скорость оседания (седиментации) – для частиц размером от 10 до 100 мкм = 0, 03 – 0, 3 м/сек. – для частиц размером ≤ 5 мкм формируют практически не седиментирующий аэрозоль; 2) проникающая способность – частицы размером 0, 05 – 5 мкм – наиболее опасны т. к. способны задерживаться бронхиолах и альвеолах. – частицы размером ≥ 10 мкм задерживаются в верхних отделах дыхательных путей и выводятся из них.
Микробный аэрозоль – это взвесь в воздухе живых или убитых микробных клеток, адсорбированных на пылевых частицах или заключенных в «капельные ядра» . Включает частицы размером от 0, 001 до 100 мкм. Размер частиц определяет 2 важных параметра аэрозоля: 1) скорость оседания (седиментации) – для частиц размером от 10 до 100 мкм = 0, 03 – 0, 3 м/сек. – для частиц размером ≤ 5 мкм формируют практически не седиментирующий аэрозоль; 2) проникающая способность – частицы размером 0, 05 – 5 мкм – наиболее опасны т. к. способны задерживаться бронхиолах и альвеолах. – частицы размером ≥ 10 мкм задерживаются в верхних отделах дыхательных путей и выводятся из них.
 Санитарно-микробиологический анализ воздуха Воздушная среда, как объект санитарномикробиологического исследования имеет целый ряд специфических особенностей: отсутствие питательных веществ → невозможность размножения микроорганизмов; Ø небольшая длительность нахождения микроорганизмов в воздушной фазе; их самопроизвольная седиментация; Ø невысокие концентрации микроорганизмов в воздухе; Ø малое разнообразие видов микроорганизмов, обнаруживаемых в воздухе. Ø
Санитарно-микробиологический анализ воздуха Воздушная среда, как объект санитарномикробиологического исследования имеет целый ряд специфических особенностей: отсутствие питательных веществ → невозможность размножения микроорганизмов; Ø небольшая длительность нахождения микроорганизмов в воздушной фазе; их самопроизвольная седиментация; Ø невысокие концентрации микроорганизмов в воздухе; Ø малое разнообразие видов микроорганизмов, обнаруживаемых в воздухе. Ø
 Санитарно-микробиологический анализ воздуха Объектами санитарно-бактериологического исследования являются: воздух лечебно-профилактических и детских учреждений, мест массового скопления людей. Нормы микробного числа в воздухе лечебно-профилактических учреждений: Операционные до начала работы – не >500; • Операционные во время работы - не > 1000; • Родильные комнаты - не > 1000; • Палаты для недоношенных детей - не > 750. • Streptococcus Санитарно-показательные микроорганизмы: стафилококки, стрептококки, сапрофитные бактерии. Staphylococcus
Санитарно-микробиологический анализ воздуха Объектами санитарно-бактериологического исследования являются: воздух лечебно-профилактических и детских учреждений, мест массового скопления людей. Нормы микробного числа в воздухе лечебно-профилактических учреждений: Операционные до начала работы – не >500; • Операционные во время работы - не > 1000; • Родильные комнаты - не > 1000; • Палаты для недоношенных детей - не > 750. • Streptococcus Санитарно-показательные микроорганизмы: стафилококки, стрептококки, сапрофитные бактерии. Staphylococcus
 Методы отбора проб воздуха Седиментационный заключается в способности микроорганизмов под действием силы тяжести и под влиянием движения воздуха оседать на поверхность питательной среды в открытые чашки Петри Аспирационный основан на принудительном осаждении микроорганизмов из воздуха на поверхность плотной питательной среды или в улавливающую жидкость
Методы отбора проб воздуха Седиментационный заключается в способности микроорганизмов под действием силы тяжести и под влиянием движения воздуха оседать на поверхность питательной среды в открытые чашки Петри Аспирационный основан на принудительном осаждении микроорганизмов из воздуха на поверхность плотной питательной среды или в улавливающую жидкость
 Дезинфекция воздуха Механическая Биологическая чистка предметов, влажная уборка, стирка, выколачивание, вытряхивание, фильтрация, вентиляция уничтожение возбудителей инфекционных болезней во внешней среде средствами биологической природы. Физическая уничтожение возбудителей на объектах происходит под влиянием различных физических факторов. Открытые УФ-облучатели Химическая применении различных химических веществ, вызывающих гибель микроорганизмов в воздухе и различных субстратах Химические дезинфектанты
Дезинфекция воздуха Механическая Биологическая чистка предметов, влажная уборка, стирка, выколачивание, вытряхивание, фильтрация, вентиляция уничтожение возбудителей инфекционных болезней во внешней среде средствами биологической природы. Физическая уничтожение возбудителей на объектах происходит под влиянием различных физических факторов. Открытые УФ-облучатели Химическая применении различных химических веществ, вызывающих гибель микроорганизмов в воздухе и различных субстратах Химические дезинфектанты
 Микробиоценозы почв
Микробиоценозы почв
 Микроорганизмы почв n Почва является естественной средой обитания микроорганизмов, которые принимают участие в процессах формирования и очищения почвы, а также круговорота веществ в природе. n Жизнедеятельность микроорганизмов в почве, их качественный и количественный состав определяется почвенными условиями: наличием питательных веществ, влажностью, аэрацией, реакцией среды, температурой и т. д. n Почва – гетерогенная среда обитания микроорганизмов. Почвенные микроорганизмы обитают в трехфазной полидисперсной среде, представленной твердой (минеральные и органические частицы), жидкой (почвенная вода) и газообразной (почвенный воздух) фазами. n Большое влияние, как на общую численность, так и на соотношение отдельных систематических групп микроорганизмов оказывает тип почвы. n На микробиоценоз почвы существенно влияет деятельность человека. Другим источником воздействий на микрофлору почв является сам субстрат. Схема строения структурной почвы как среды обитания микроорганизмов (по Д. Г. Звягинцеву, 1987): 1 – почвенный агрегат; 2 – органическое вещество; 3 – пленка воды; 4 – внутриагрегатная пора; 5 – межагрегатная пора; 6 – микроорганизмы.
Микроорганизмы почв n Почва является естественной средой обитания микроорганизмов, которые принимают участие в процессах формирования и очищения почвы, а также круговорота веществ в природе. n Жизнедеятельность микроорганизмов в почве, их качественный и количественный состав определяется почвенными условиями: наличием питательных веществ, влажностью, аэрацией, реакцией среды, температурой и т. д. n Почва – гетерогенная среда обитания микроорганизмов. Почвенные микроорганизмы обитают в трехфазной полидисперсной среде, представленной твердой (минеральные и органические частицы), жидкой (почвенная вода) и газообразной (почвенный воздух) фазами. n Большое влияние, как на общую численность, так и на соотношение отдельных систематических групп микроорганизмов оказывает тип почвы. n На микробиоценоз почвы существенно влияет деятельность человека. Другим источником воздействий на микрофлору почв является сам субстрат. Схема строения структурной почвы как среды обитания микроорганизмов (по Д. Г. Звягинцеву, 1987): 1 – почвенный агрегат; 2 – органическое вещество; 3 – пленка воды; 4 – внутриагрегатная пора; 5 – межагрегатная пора; 6 – микроорганизмы.
 Микроорганизмы почв n n n В составе микрофлоры почвы выделяют следующие функциональные группы микроорганизмов: сапрофитная (зимогенная) микрофлора – разлагает органические соединения, автохтонная – разлагает гумус, осуществляет минерализацию сложных органических соединений, олиготрофная – ассимилирует питательные вещества из растворов с низкой концентрацией, завершая минерализацию, автотрофная (хемоавтотрофная) – вызывает окисление неорганических соединений, образующихся при миробной трансформации органических веществ. Структура микробного ценоза почвы: А– зимогенная микрофлора; Б – автохтонная микрофлора; В – олиготрофные бактерии; Г – автотрофные бактерии
Микроорганизмы почв n n n В составе микрофлоры почвы выделяют следующие функциональные группы микроорганизмов: сапрофитная (зимогенная) микрофлора – разлагает органические соединения, автохтонная – разлагает гумус, осуществляет минерализацию сложных органических соединений, олиготрофная – ассимилирует питательные вещества из растворов с низкой концентрацией, завершая минерализацию, автотрофная (хемоавтотрофная) – вызывает окисление неорганических соединений, образующихся при миробной трансформации органических веществ. Структура микробного ценоза почвы: А– зимогенная микрофлора; Б – автохтонная микрофлора; В – олиготрофные бактерии; Г – автотрофные бактерии
 Микроорганизмы почв n В составе микрофлоры почвы выделяют следующие группы микроорганизмов: n бактерии аммонификаторы – вызывают гниение трупов животных, остатков растений, разложение мочевины с образованием аммиака и других продуктов (B. subtilis , B. mesentericus , Serratia marcescens ; бактерии рода Proteus ; грибы рода Aspergillus , Mucor , Penicillium ; C. sporogenes , C. putrificum ; Urobacillus pasteuri , Sarcina urea); n нитрифицирующие бактерии – окисляет аммиак до азотистой кислоты с образованием нитритов (Nitrosomonas), превращают азотистую кислоту в азотную и нитраты(Nitrobacter); n азотфиксирующие бактерии – усваивают из воздуха свободный кислород и из молекулярного азота синтезируют белки и другие органические соединения азота, используемые растениями; n бактерии, участвующие в круговороте серы, железа, фосфора и других элементов – серобактерии, железобактерии и т. д. ; n бактерии, расщепляющие клетчатку, вызывающие брожение (молочнокислые, спиртовые, маслянокислые, уксусные, пропионовые и др. ).
Микроорганизмы почв n В составе микрофлоры почвы выделяют следующие группы микроорганизмов: n бактерии аммонификаторы – вызывают гниение трупов животных, остатков растений, разложение мочевины с образованием аммиака и других продуктов (B. subtilis , B. mesentericus , Serratia marcescens ; бактерии рода Proteus ; грибы рода Aspergillus , Mucor , Penicillium ; C. sporogenes , C. putrificum ; Urobacillus pasteuri , Sarcina urea); n нитрифицирующие бактерии – окисляет аммиак до азотистой кислоты с образованием нитритов (Nitrosomonas), превращают азотистую кислоту в азотную и нитраты(Nitrobacter); n азотфиксирующие бактерии – усваивают из воздуха свободный кислород и из молекулярного азота синтезируют белки и другие органические соединения азота, используемые растениями; n бактерии, участвующие в круговороте серы, железа, фосфора и других элементов – серобактерии, железобактерии и т. д. ; n бактерии, расщепляющие клетчатку, вызывающие брожение (молочнокислые, спиртовые, маслянокислые, уксусные, пропионовые и др. ).
 Микробное загрязнение почв q q Через почву могут передаваться Резиденты (почва Загрязняющие почву с выделениями возбудители многих служит Сохраняются инфекционных природным длительно недолго заболеваний, в том биотопом) числе столбняк, газовая Clostridium Bacillus anthracis, Виды Salmonella, гангрена, ботулизм. botulinum, Clostridium tetani Shigella, Vibrio, Особо опасным в виды Clostridium, Brucella, возбудители санитарном отношении Mycobacterium, подкожных вызывающие является загрязнение микозов, виды Leptospira, анаэробные почвы Actinomyces, инфекции Pseudomonas необезвреженными некоторые энтеровирусы, отходами возбудители вирус ящура животноводства (навоз, моча, трупы животных). микотоксикозов q Обезвреживание почвы, обсемененной патогенными микроорганизмами, проводят механической обработкой и посевом растений. Применение химических веществ приводит к утрате почвой плодородия.
Микробное загрязнение почв q q Через почву могут передаваться Резиденты (почва Загрязняющие почву с выделениями возбудители многих служит Сохраняются инфекционных природным длительно недолго заболеваний, в том биотопом) числе столбняк, газовая Clostridium Bacillus anthracis, Виды Salmonella, гангрена, ботулизм. botulinum, Clostridium tetani Shigella, Vibrio, Особо опасным в виды Clostridium, Brucella, возбудители санитарном отношении Mycobacterium, подкожных вызывающие является загрязнение микозов, виды Leptospira, анаэробные почвы Actinomyces, инфекции Pseudomonas необезвреженными некоторые энтеровирусы, отходами возбудители вирус ящура животноводства (навоз, моча, трупы животных). микотоксикозов q Обезвреживание почвы, обсемененной патогенными микроорганизмами, проводят механической обработкой и посевом растений. Применение химических веществ приводит к утрате почвой плодородия.
Санитарно-микробиологический анализ почв При исследовании почвы может проводиться полный или краткий анализ. Полный санитарно-бактериологический анализ почвы проводится: nдля подробной и глубокой характеристики санитарного состояния почвы; nдля определения пригодности почвы при размещении жилья, мест отдыха, детских учреждений и водопроводных сооружений; nдля эпидемиологических исследований. Дополнительно: определение актиномицетов, грибов, сальмонелл, шигелл, возбудителей столбняка, ботулизма, бруцеллеза, сибирской язвы. Краткий анализ рекомендуется при осуществлении текущего санитарного надзора и включает определение общего количества сапрофитных бактерий, клостридий (перфрингенститр), термофильных бактерий.
Санитарно-микробиологический анализ почв При исследовании почвы может проводиться полный или краткий анализ. Полный санитарно-бактериологический анализ почвы проводится: nдля подробной и глубокой характеристики санитарного состояния почвы; nдля определения пригодности почвы при размещении жилья, мест отдыха, детских учреждений и водопроводных сооружений; nдля эпидемиологических исследований. Дополнительно: определение актиномицетов, грибов, сальмонелл, шигелл, возбудителей столбняка, ботулизма, бруцеллеза, сибирской язвы. Краткий анализ рекомендуется при осуществлении текущего санитарного надзора и включает определение общего количества сапрофитных бактерий, клостридий (перфрингенститр), термофильных бактерий.
 Определение перфрингенс-титра Перфрингенс-титр – наименьшее весовое количество почвы, выраженное в граммах, в котором обнаруживается жизнеспособная клетка Clostridium perfringens. Определение перфрингенс-титра является важным критерием для санитарной оценки почвы и ее самоочищения, так как при фекальном загрязнении почвы уже через 4 -5 месяцев E. coli исчезают, а Cl. perfringens обнаруживаются в титре 0, 01 г. Clostridium perfringens
Определение перфрингенс-титра Перфрингенс-титр – наименьшее весовое количество почвы, выраженное в граммах, в котором обнаруживается жизнеспособная клетка Clostridium perfringens. Определение перфрингенс-титра является важным критерием для санитарной оценки почвы и ее самоочищения, так как при фекальном загрязнении почвы уже через 4 -5 месяцев E. coli исчезают, а Cl. perfringens обнаруживаются в титре 0, 01 г. Clostridium perfringens


